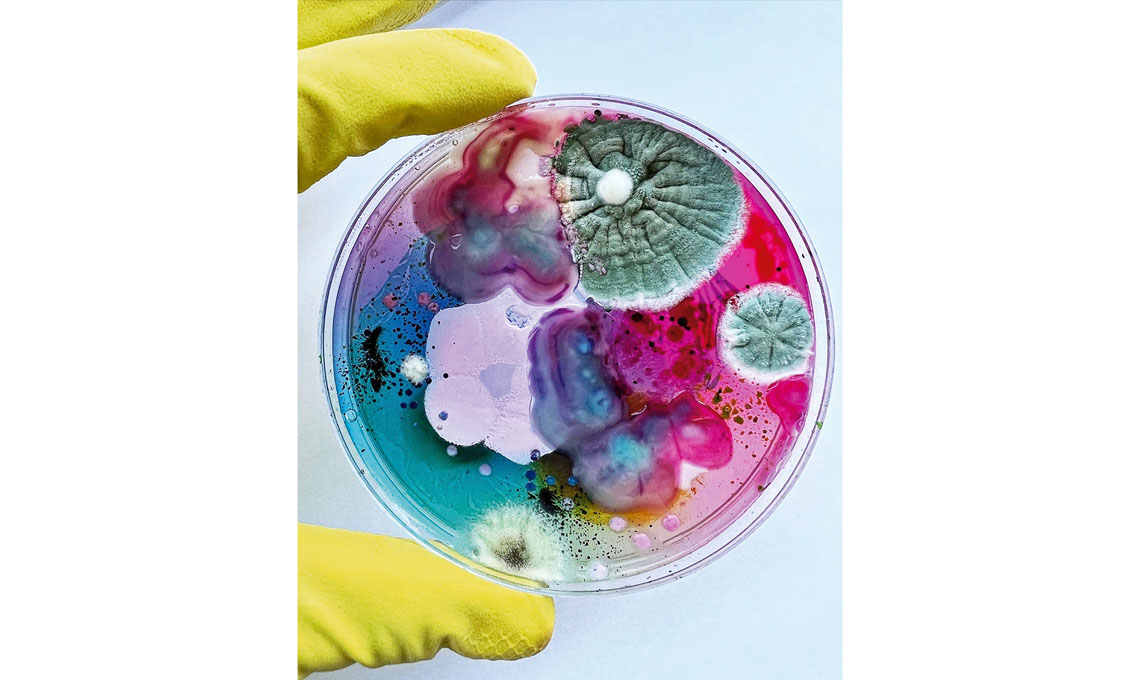

Le muffe si riproducono tramite le spore che si depositano sulle superfici e si moltiplicano quando trovano le condizioni ideali. Si diffondono nell’aria e solitamente non possono essere viste a occhio nudo, ma sono ovunque. Un mondo fisico che è un po’ metafisico...
Élodie Antoine è un’artista di sculture morbide. Con i suoi funghi tessili, contamina un luogo scuotendone l’ordine stabilito, suscitando sentimenti di curiosità, attrazione e repulsione.
Michael McGrath ama rappresentare il misticismo, renderlo visibile con la sua arte fatta di simboli tra bene e male, inseriti nel nostro paesaggio e in natura. Ecco qui uno dei suoi ‘Brontoloni in agguato’ (No. 2.) personaggi ultraterreni a grandezza umana.
Daria Fedorova sviluppa una metodologia unica di coltivazione artistica di microrganismi. Mostra, combina e plasma le spore in splendide composizioni artistiche.